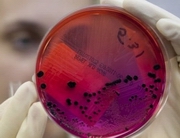

|
Казахстанские новостиТри случая сибирской язвы зафиксировали в Алматинской области (05.07.2016, 20:22), просмотров: 4022
По
данным на 8 июня 2016 года, в Кербулакском районе Алматинской области
зарегистрировано три случая кожной формы сибирской язвы. Об этом
сообщили в пресс-службе Управления здравоохранения региона в ответе на
официальный запрос Tengrinews.kz. В ведомстве пояснили, что все больные
участвовали в забое и разделке туши больной коровы. Их общее состояние при поступлении оценили как средней степени тяжести. "Гемодинамика стабильная, выставлен предварительный диагноз: "Сибирская язва. Кожно-локализованная форма". Больным проводилась антибактериальная, симптоматическая, дезинтоксикационная, местная терапия. В настоящее время все больные выписаны с выздоровлением домой", - сообщили в ведомстве. Помимо этого, в результате посещения очага установлено 104 контактных лица, на всех заведены листы наблюдения и назначена антибиотикотерапия. "Среди контактных лиц больных не выявлено. Совместно с представителями ветеринарной службы, заместителем руководителя Департамента по защите прав потребителей по Алматинской области, ЧС и местным акиматом проведен сход с местным населением", - сообщили в пресс-службе. Также был проведен забор материала от больных (кровь, смывы с поверхности раны), отобраны пробы внешней среды (почва, мясо, шерсть, кожа) и направлены в особо опасную лабораторию филиала РГП на ПХВ "Национальный центр экспертизы" КЗПП МНЭ РК по Алматинской области и в Республиканскую особо опасную лабораторию Алматы. В алматинской лаборатории по результатам анализа, проведенного на ПЦР (полимеразная цепная реакция) материала от больных, выявлен возбудитель сибирской язвы. "Бактериологические исследования в работе", - прокомментировали в ведомстве. Напомним, ранее в Министерстве национальной экономики сообщили о 10 официально подтвержденных случаях сибирской язвы в Казахстане. Восемь из них зафиксированы в населенном пункте Еркиндык Карагандинской области. Двое из госпитализированных скончались. "Заражение животного могло произойти в результате выпаса вблизи неогражденного скотомогильника и неэффективной вакцинации животных против сибирской язвы. Ситуация осложнилась нерешенностью вопросов сжигания трупов павших животных в инсинераторах", - пояснили в ведомстве. Два случая - в селе Калбатау Жарминского района Восточно-Казахстанской области. Источником инфекции явилась больное сибирской язвой животное (корова). Заражение людей произошло контактным путем при участии 5 июня в забое больного животного без ветеринарного осмотра. Tengrinews Последние новости:
|
Ещё новостиСамые читаемые:
Самые обсуждаемые:
|
| Реклама на сайте | Контакты | Наши клиенты | сейчас на сайте 227 чел. | ||||
| © 2006-2023 ТОО"Электронный город" Дизайн Алексенко А. | |||||||
Комментарии:
Нет комментариев. Почему бы Вам не оставить свой?
Для того чтобы оставить комментарий зарегистрируйтесь и войдите на сайт под своим именем.
Если Вы уже регистрировались то просто войдите на сайт под своим именем.